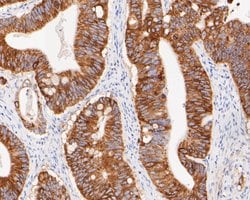
Invitrogen FAT1 Polyclonal Antibody 100 &mu;L; Unconjugated:Antibodies,

missing translation for 'onlineSavingsMsg'
Learn More
Learn More
Invitrogen™ FAT1 Polyclonal Antibody


Rabbit Polyclonal Antibody
Brand: Invitrogen™ PA5141151
This item is not returnable.
View return policy
Description
FAT1 Polyclonal Antibody for Western Blot, IHC (P)
This gene is an ortholog of the Drosophila fat gene, which encodes a tumor suppressor essential for controlling cell proliferation during Drosophila development. The gene product is a member of the cadherin superfamily, a group of integral membrane proteins characterized by the presence of cadherin-type repeats. In addition to containing 34 tandem cadherin-type repeats, the gene product has five epidermal growth factor (EGF)-like repeats and one laminin A-G domain. This gene is expressed at high levels in a number of fetal epithelia. Its product probably functions as an adhesion molecule and/or signaling receptor, and is likely to be important in developmental processes and cell communication. Transcript variants derived from alternative splicing and/or alternative promoter usage exist, but they have not been fully described.
Specifications
| FAT1 | |
| Polyclonal | |
| Unconjugated | |
| FAT1 | |
| 2310038E12Rik; AU023433; Cadherin family member 7; cadherin FAT1 isoform +12; cadherin ME5; cadherin-related family member 8; cadherin-related tumor suppressor homolog; CDHF7; CDHR8; FAT; fat 1 cadherin; FAT atypical cadherin 1; FAT tumor suppressor 1; FAT tumor suppressor homolog 1; FAT tumor suppressor homolog 1 (Drosophila); FAT1; Fath; hFat1; ME5; mFat1; Protein fat homolog; protocadherin Fat 1; Protocadherin Fat 1, nuclear form | |
| Rabbit | |
| Antigen affinity chromatography | |
| RUO | |
| 2195 | |
| Store at 4°C short term. For long term storage, store at -20°C, avoiding freeze/thaw cycles. | |
| Liquid |
| Immunohistochemistry (Paraffin), Western Blot | |
| 1 mg/mL | |
| TBS with 0.2% BSA, 50% glycerol and 0.05% sodium azide; pH 7.4 | |
| Q14517 | |
| FAT1 | |
| Synthetic peptide within Human Protocadherin Fat 1 aa 238-287/4,588. | |
| 100 μL | |
| Primary | |
| Human | |
| Antibody | |
| IgG |
Product Content Correction
Your input is important to us. Please complete this form to provide feedback related to the content on this product.
Product Title
Spot an opportunity for improvement?Share a Content Correction